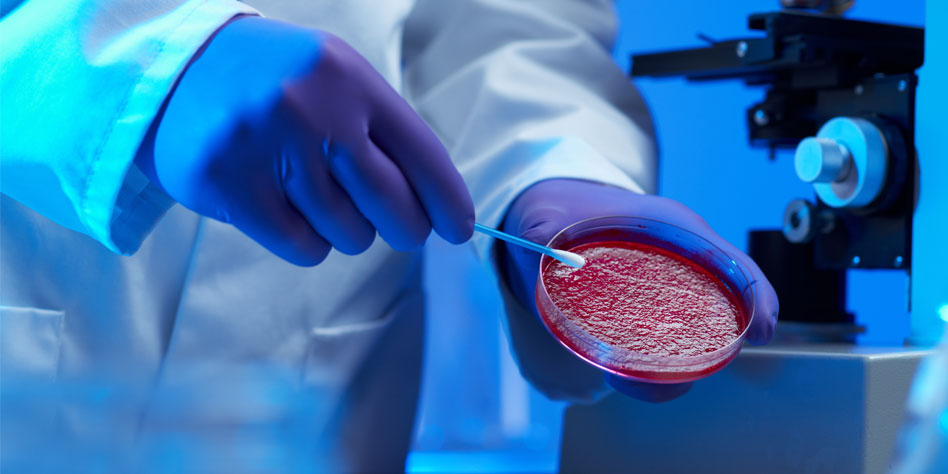
hero-image-full-biosecurity.jpg

Notre laboratoire a vu le jour, suite à des réformes entreprises par notre ministère de tutelle pour promouvoir la recherche scientifique dans les établissements universitaires et centres de recherche en Algérie (à travers la DGRSDT), tout en faisant émerger des structures d’encadrement plus performantes en termes de prestations, du point de vue de la formation tant académique que professionnelle, structures dans lesquelles les enseignants-chercheurs peuvent s’organiser et s’exprimer (mettre en exergue l’impact socio-économique).
Il a été agréé en octobre 2007 avec pour missions d’une part, la formation de jeunes chercheurs pour une maîtrise d’un maximum d’outils analytiques classiques ou de pointe et ce, à travers des formations doctorales et des projets de recherche proposés pour agrément ou en cours de réalisation (PRFU, PNR, Projets à Impact socio-économique, CRSTRA…), et aussi des accords de coopération entrepris avec des partenaires universitaires Algériens et étrangers. D’autre part, il nous incombe d’offrir à cours terme les services de notre laboratoire à l’ensemble des chercheurs de notre établissement, et à moyen terme pour les autres secteurs hors université. Ces objectifs sont le reflet des actions scientifiques suivantes :
- Optimisation des conditions analytiques pour l’évaluation de la qualité des eaux avant et après les différents traitements par des matériaux locaux (mise au point de pilotes de traitement).
- Valorisation des plantes sahariennes par la Caractérisation analytique des produits naturels à utilité médicale (Contribution à l’élaboration des principes actifs de certaines plantes).
- Caractérisation des interactions : Climat – Végétation – Sol – Eau.
- Évaluation de la qualité des sols en milieux désertiques.
Notre devise se résume à travers les mots clés suivants : Partage et complémentarité, fidélité et rigueur scientifique.
Présentation du laboratoire BMD
Le laboratoire ‘Biogéochimie des milieux désertiques’ est localisé dans la Faculté des Mathématiques et des Sciences de la matière. Il occupe actuellement une superficie de deux fois 80 m². Il dispose, sur le plan matériel, d’équipements analytiques plus ou moins récents (Spectrophotomètre à absorption atomique, Spectrophotomètre UV-Visible, Spectrophotomètre Infrarouge à Transformée de Fourrier, Chromatographe en phase liquide «HPLC» et un autre, en phase gazeuse couplé à un spectromètre de masse « GC-MS », en plus du petit matériel nécessaire aux extractions et aux analyses simples.
Le laboratoire a vécu 3 réaménagements entre 2009 et 2011 puisque les trois premiers chefs d’équipe ont créé 3 nouveaux laboratoires au vu de la pluridisciplinarité de l’effectif initial.
Actuellement, notre laboratoire est composé de 51 membres, dont 3 Professeurs, 15 Maîtres de conférences, 08 Maîtres-assistants, 24 Doctorants (dont 13 LMD) et un seul personnel de soutien (comptabilité) commun à deux laboratoires.
Il est organisé en 4 équipes de recherche, à savoir :
Equipe 1: Analyses physicochimiques des produits naturels . Dirigée par M. HADJ MAHAMMED Mahfoud. Avec un axe orienté vers la caractérisation et l’analyse de quelques familles de produits naturels (flavonoïdes, alcaloïdes et terpènes) des plantes choisies suite à un inventaire préétabli.
Equipe 2 : Analyses et traitement des eaux. Dirigée par M. SEKIRIFA Mohamed Lamine.
Elle se focalise sur le suivi analytique (physico-chimique et biologique) des eaux et de différentes sources de pollution, répertorie les différents polluants (surtout organiques) en milieu saharien, et travaille à la mise en place de prototypes de traitement des eaux usées tout en exploitant les ressources naturelles de la région (matériaux d’adsorption et de filtration).
Equipe 3 : Valorisation des plantes médicinales et phytochimie. Dirigée par Mme BOUZIANE Mebarka. L’axe développé étant l’étude phytochimique et la mise en évidence de quelques principes actifs des plantes sahariennes à caractère médicinal à travers divers types de tests biologiques.
En d’autres termes, les travaux du laboratoire visent en majorité à développer de nouveaux procédés ou à optimiser des procédés déjà existants, ainsi qu’à mettre en valeur de nouveaux matériaux, tels que les nouveaux absorbants.
Dans le cadre de différents partenariats, le laboratoire a entrepris des collaborations avec des centres de recherche locaux (CRAPC, INRAA et CRSTRA) et internationaux tels que le Centre National de Recherche et de Formation sur le Paludisme (CNRFP), Ouagadougou, (Burkina Faso) et INRA (France)..
Objectifs
Tels que cités dans le mot du directeur, Le Laboratoire ‘BMD’ s’est fixé pour missions :
- Formation des jeunes chercheurs (doctorants et mastérants) pour une maîtrise d’un maximum d’outils analytiques classiques et de pointe.
- Contribution à la Valorisation de diverses ressources naturelles sahariennes.
- Offre de services (selon compétence) à l’ensemble des chercheurs universitaires et des autres secteurs hors université.

.jpg)











